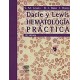
DACIE Y LEWIS HEMATOLOGIA PRACTICA

DACIE Y LEWIS HEMATOLOGIA PRACTICA
9788480862295
Más información
Esta 10ª ed. es la obra de referencia por excelencia en el campo delLaboratorio de Hematología. - Recoge todas las técnicas utilizadas para lainvestigación de los desórdenes tanto en el sistema hematopoyéticocomo hemostático. - Perfectamente estructurada y organizada, incluye una reseñade las webs más importantes relacionadas conHematología.
Contenidos
Obra reconocida mundialmente como la 'biblia' de lahematología, que se presenta en forma de manual y que en su 10ª ed es la obra de referencia por excelencia en el campo delLaboratorio de Hematología. La obra recoge todas las técnicas utilizadas parala investigación de los desórdenes tanto en el sistema hematopoyéticocomo hemostático. Se trata de una obra bien organizada, con capítulos dedicadosa todas las áreas que se pueden encontrar en un laboratorio de Hematología: hematimetría, citología hematológica, hemostasia, estudiode anemias, inmunofenotipado, citogenética, biologíamolecular y banco de sangre. Cada capítulo está estructurado en apartados yposee un índice al inicio que resulta de mucha utilidad para conocer deantemano todo el contenido del mismo. La exposición de los conceptos es clara yconcisa, presentando también un importante número de esquemas muy válidos eilustraciones de calidad óptima. Igualmente, cada capítulo posee un buen númerode citas bibliográficas con una correcta actualización. En el libro también sehace una reseña de las webs más importantesrelacionadas con Hematología, incluyendo también las vinculadas a losdispositivos o kits de reactivos utilizados.
Índicede capítulos
1. Recogida y manipulación de sangre.
2. Intervalos de referencia yvalores normales.
3. Técnicas hematológicas básicas.
4. Métodos de preparación y tinciónde las extensiones sanguíneas y de la médula ósea.
5. Morfología de las célulassanguíneas normales y patológicas.
6. Biopsia de la médula ósea.
7. Anemia ferropénicay sobrecarga de hierro .
8. Investigación del estado de la cobalamina, el folato y losmetabolitos en la anemia magaloblástica.
9. Métodos de laboratorioutilizados para la investigación de las anemias hemolíticas.
10. Investigación de las anemiashemolíticas hereditarias: anomalías enzimáticas.
11. Anemias hemolíticas adquiridas.
12. Investigación de lashemoglobinas anómalas y de las talasemias.
13. Citoquímicaeritrocitaria y leucocitaria.
14. Inmunofenotipado.
15. Radioisótopos en el diagnósticohematológico.
16. Exploración de la hemostasia.
17. Investigación de la tendencia trombótica.
18. Control de laboratorio de laterapia anticoagulante, trombolítica y antiplaquetaria.
19. Antígenos y anticuerpos de lascélulas sanguíneas: eritrocitos, plaquetas y granulocitos.
20. Aspectos de laboratorio de lastransfusiones sanguíneas.
21. Análisis molecular y citogenético.
22. Miselánea.
23. Aproximación al diagnóstico yclasificación de los trastornos hemotológicos.
24. Organización y gestión dellaboratorio.
25. Seguridad en el laboratorio.
26. Control de calidad.
27. Hematología en laboratorios derecursos escasos.
28. Apéndices. Índice alfabético.
Reseñas
No hay reseñas de clientes en este momento.
30 otros productos de la misma categoría:
LibreriaMedica.es
 Conócenos
Conócenos Estudiantes
 Estudiantes
Estudiantes